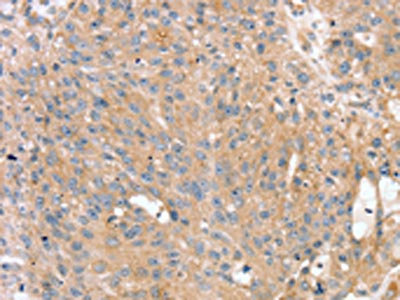

PTX3 Antibody
-
中文名稱:PTX3兔多克隆抗體
-
貨號:CSB-PA508112
-
規格:¥1100
-
圖片:
-
The image on the left is immunohistochemistry of paraffin-embedded Human esophagus cancer tissue using CSB-PA508112(PTX3 Antibody) at dilution 1/40, on the right is treated with synthetic peptide. (Original magnification: ×200)
-
The image on the left is immunohistochemistry of paraffin-embedded Human breast cancer tissue using CSB-PA508112(PTX3 Antibody) at dilution 1/40, on the right is treated with synthetic peptide. (Original magnification: ×200)
-
Gel: 8%SDS-PAGE, Lysate: 40 μg, Lane: Human normal lung tissue, Primary antibody: CSB-PA508112(PTX3 Antibody) at dilution 1/400, Secondary antibody: Goat anti rabbit IgG at 1/8000 dilution, Exposure time: 20 seconds
-
-
其他:
產品詳情
-
Uniprot No.:
-
基因名:PTX3
-
別名:AI607804 antibody; Pentaxin 3 antibody; Pentaxin-related protein PTX3 antibody; Pentraxin 3 long antibody; Pentraxin-related gene antibody; Pentraxin-related gene rapidly induced by IL-1 beta antibody; Pentraxin-related protein PTX3 antibody; PTX3 antibody; PTX3_HUMAN antibody; TNF alpha-induced protein 5 antibody; TNFAIP5 antibody; TSG-14 antibody; TSG14 antibody; Tumor necrosis factor alpha-induced protein 5 antibody; Tumor necrosis factor-inducible gene 14 protein antibody; Tumor necrosis factor-inducible protein TSG-14 antibody
-
宿主:Rabbit
-
反應種屬:Human,Mouse
-
免疫原:Synthetic peptide of Human PTX3
-
免疫原種屬:Homo sapiens (Human)
-
標記方式:Non-conjugated
-
抗體亞型:IgG
-
純化方式:Antigen affinity purification
-
濃度:It differs from different batches. Please contact us to confirm it.
-
保存緩沖液:-20°C, pH7.4 PBS, 0.05% NaN3, 40% Glycerol
-
產品提供形式:Liquid
-
應用范圍:ELISA,WB,IHC
-
推薦稀釋比:
Application Recommended Dilution ELISA 1:1000-1:2000 WB 1:200-1:1000 IHC 1:25-1:100 -
Protocols:
-
儲存條件:Upon receipt, store at -20°C or -80°C. Avoid repeated freeze.
-
貨期:Basically, we can dispatch the products out in 1-3 working days after receiving your orders. Delivery time maybe differs from different purchasing way or location, please kindly consult your local distributors for specific delivery time.
-
用途:For Research Use Only. Not for use in diagnostic or therapeutic procedures.
相關產品
靶點詳情
-
功能:Plays a role in the regulation of innate resistance to pathogens, inflammatory reactions, possibly clearance of self-components and female fertility.
-
基因功能參考文獻:
- PTX3 might be an early marker of cardiovascular mortality in patients with advanced chronic kidney disease yet before the increase of specific marker for systemic inflammation like hsCRP. PMID: 28377558
- These findings reveal that the CRP- and PTX3-binding characteristics of FHL-1 differ from those of FH, likely underpinning independent immune regulatory functions in the context of the human retina. PMID: 29374201
- given that acute aerobic exercise reduced the ex vivo production of PTX3 in both groups PMID: 28440716
- PTX3 is not suitable to serve as an indicator of thrombolytic efficacy and had no association with long-term prognosis in stroke patients receiving thrombolytic therapy. PMID: 29949524
- Patients with TAO showed increased presence of PTX3 in orbital tissue and serum. PMID: 29675428
- Data show that pentraxin-3 (PTX3) is not a biomarker of disease activity and cannot be used for the purpose. PMID: 28043168
- PTX3 is positively regulated by chronic hyperglycemia but negatively regulated by aldosterone PMID: 29715313
- treatment of human osteoblast primary cultures derived from young patients with anti-PTX3 antibody, osteoblasts lost the morphological and molecular features typical of mature osteoblasts, acquiring fibroblast-like shape and highly decreasing nuclear factor kappa-B ligand (RANKL) and RUNX2 expression. PMID: 29022895
- High PTX3 expression is associated with endothelial dysfunction during hemodialysis. PMID: 27915246
- PTX3 might be an inflammatory biomarker for coronary artery disease. PTX3 was associated with the severity of coronary artery stenosis. PMID: 28778748
- plasma level increased as pregnancy progressed PMID: 28421853
- Results showed that increased PTX3 expression was significantly associated with tumor grade in human cervical cancer cells. It also demonstrated that PTX3 contributes to tumorigenesis and metastasis of cervical cancer cells. PMID: 27377307
- serum level increased in pre-eclampsia PMID: 28569615
- serum PTX-3 level might be a significant mediator in childhood-onset systemic lupus erythematosus (cSLE); the results support that PTX3 reflects active cutaneous vasculitis in cSLE and correlates with disease activity. PMID: 28420068
- Serum PTX3 is related to the severity of autoimmune hepatitis, the presence of acute-on-chronic liver failure and 90-day mortality. PMID: 28809733
- Knocking down long pentraxin-3 (PTX3) or vimentin repressed oleate-induced head and neck squamous cell carcinomas (HNSCCs) invasion. PMID: 28489600
- Higher levels of PTX3 in women with preeclampsia were significantly associated with signs of adverse arterial effects during pregnancy. PMID: 28377191
- PTX3 is associated with bacterial infection in patients with COPD. PMID: 28458531
- Suggest that PTX3 plasma level at graft-versus-host disease occurrence is a robust onset biomarker and correlates with both maximum disease severity and response to corticosteroid treatment. PMID: 27893415
- Plasma PTX3 level was elevated at the early stage of the exercise training intervention, and was subsequently associated with training-induced alteration of arterial stiffness in middle-aged and older adults. PMID: 26467819
- White coat hypertension is characterized by increased PTX-3 levels. PMID: 26040439
- Serum PTX3 concentrations are correlated with diabetic nephropathy. PMID: 27233528
- Data show that miR-29c-3p and PTX3 are inversely correlated in tissues and meningioma cells, suggesting that PTX3 can be regulated by miR-29c-3p. PMID: 28327132
- Elevated levels of pentraxin-3, fetuin-A, CRP, ESR might play a role in the pathogenesis of rheumatoid arthritis. Levels of fetuin-A, insulin HOMA-IR, pentraxin-3, CRP and ESR were not associated with clinical severity of the rheumatoid arthritis. PMID: 27152709
- High PTX3 expression is associated with lung graft dysfunction. PMID: 27421969
- JAK2V617F mutation influences myeloproliferative neoplasm -associated inflammation with a strong correlation between allele burden and PTX3 levels. Plasma levels of hs-CRP and PTX3 might be of prognostic value for patients with ET and PV PMID: 28228104
- This study demonstrated that PTX3 plays an important role in glioma cell proliferation and invasion, and may thus serve as a novel potential therapeutic target in the treatment of gliomas. PMID: 27278519
- PTX-3 blood level valuably discriminates the different stages of sepsis severity during the first week of intensive care treatment. PMID: 28793880
- abundance is stimulated, in part, through AKT- and nuclear factor kappaB (NF-kappaB)-dependent pathways and that presence of PTX3 is necessary for PI3K-induced stem cell-like traits. PMID: 28223411
- This is the first study showing that adolescent male swimmers have higher PTX3 levels than sedentary controls and that there is a linear relationship between PTX3 and GDF-15. PMID: 28664745
- These findings provide evidence supporting the role of PTX3 as a mediator of the anti-inflammatory response in physiologically relevant conditions, and suggests that PTX3 counter regulates the development of atherosclerosis by enhancing the production of IL-10. PMID: 27450429
- Endothelium, when exposed to high density circulating angiogenic cells, releases PTX3 which markedly impairs the vascular regenerative response in an autocrine manner. PMID: 27659714
- Serum PTX3 levels were higher in non-obese rheumatoid arthritis patients than in obese. PMID: 27404695
- PTX3 concentrations were significantly higher in the adrenal tumor group compared with the control group. PTX3 concentrations were positively correlated with carotid intima media thickness, systolic and diastolic blood pressure, and urinary metanephrine concentrations. Serum PTX3 concentrations increased in both functional and nonfunctional adrenal tumors. PMID: 28332877
- patients with inflammatory rheumatic diseases have increased s-PTX3 levels, which, in contrast to other inflammatory markers, do not seem to improve within 6 months of therapy with methotrexate and/or anti-TNF. PMID: 28225768
- median serum PTX3 is lower in systemic lupus erythematosus patients (especially when IFN-alpha is detectable) compared to blood donors PMID: 28257596
- PTX3 may bridge the humoral arms of the innate and adaptive immune systems by serving as an endogenous adjuvant for marginal zone B cells. PMID: 27621420
- PTX3 levels increase in the airways of patients with severe asthma and OVA-exposed mice. Deletion of PTX3 results in enhanced inflammation, airway hyper-responsiveness, and mucus production on OVA sensitization and challenge. PMID: 27567326
- Data suggest that modest weight loss in overweight adults due to caloric restriction and exercise decreases serum leptin (LEP) and high molecular weight adiponectin (ADPN), and increases serum pentraxin-3 (PTX3) in a manner that correlates with increased insulin sensitivity. PMID: 27605038
- IL-6 trans-signaling and PTX3 amplification at the site of inflammation could have a role in pathophysiological mechanisms of Peyronie's disease. PMID: 28359407
- Serum/plasma levels of PTX3 in autoimmune diseases were higher than in normal controls. PMID: 27255354
- The genotype frequencies of rs2305619 and rs2120243 differed significantly between the Diabetic Nephropathy and the Non Diabetic Nephropathy groups. Patients with the GG variant of rs2305619 showed 4.078-fold higher susceptibility to DN than those with the AA variant (OR=4.078, 95% CI=1.370-12.135, p=0.012); patients with AA variant of rs2120243 had a lower risk of developing DN (OR=0.213, 95% CI=0.055-0.826, p=0.025). PMID: 28119515
- We show that PTX3 levels correlate with the severity of aGVHD, cGVHD, and-with reservations-survival in patients undergoing allogeneic HSCT. PMID: 27403536
- a decrease in FGF 2 is not accompanied by increased serum pentraxin 3 levels in patients with systemic sclerosis PMID: 27878407
- PTX3 was higher in obese cases than controls (p = 0.0001). Eighty percent of the cases had Nonalcoholic Fatty Liver Disease with progressive increases in PTX3 levels as the severity of fatty liver increased (p = 0.0001). PMID: 27309736
- PTX3 is an independent prognostic indicator in colorectal cancer. PMID: 27568661
- CC genotype of rs3816527 had an obviously higher frequency in cases than in controls and had a positive effect on AS occurrence and the same was true of the C allele in rs3816527. For rs3845978, CT genotype showed a significant frequency difference between the case and control groups (P=0.03) and people with genotypes carrying the T allele developed AS earlier ), and the same was found in the analysis of the T allele. PMID: 27538101
- The level of plasma PTX3 in neonates with pulmonary arterial hypertension appears higher than those without the same diagnosis. PMID: 27838407
- Within the limitations of this study, the results seem to sustain the involvement of Pentraxin 3 and Thrombospondin 1 in the processes of inflammation and angiogenesis in wound healing of patients with postorthodontic gingivectomy. PMID: 27403446
- NF-kappaB signaling pathway may serve as potential targets for regulation of PTX3 expression in the retina. PMID: 27980366
顯示更多
收起更多
-
亞細胞定位:Secreted.
-
數據庫鏈接:
Most popular with customers
-
-
YWHAB Recombinant Monoclonal Antibody
Applications: ELISA, WB, IHC, IF, FC
Species Reactivity: Human, Mouse, Rat
-
Phospho-YAP1 (S127) Recombinant Monoclonal Antibody
Applications: ELISA, WB, IHC
Species Reactivity: Human
-
-
-
-
-